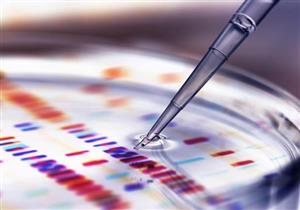
علماء يكتشفون فيروسا غامضا يدعى "يارا"

إعلان
-
12 فبراير, 2020
-
12 فبراير, 2020
-
11 فبراير, 2020
-
10 فبراير, 2020
إعلان
الجابون
موزمبيق
غينيا الاستوائية
السودان
الجزائر
بوركينا فاسو
كوت ديفوار
الكاميرون
أخبار منتخبات كأس الأمم الأفريقية

إعلان